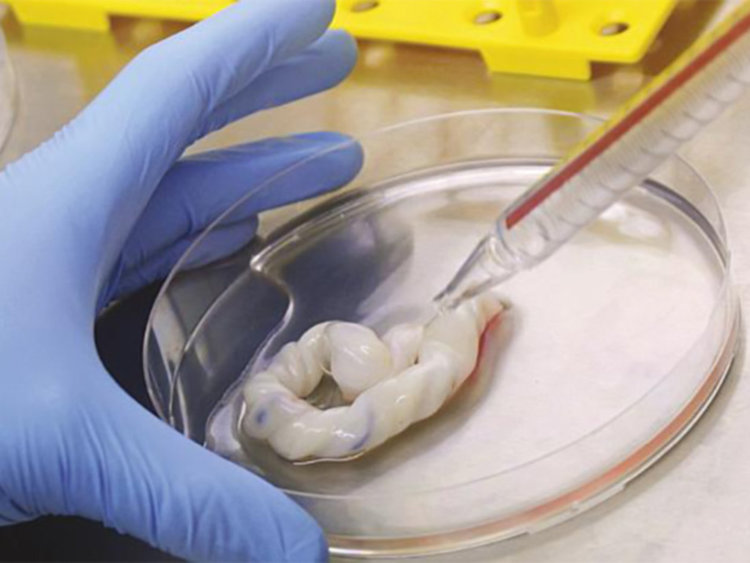
Двойно са скочили манипулациите за стволови клетки

Двойно е скочил броят на манипулациите, с които се вземат стволови клетки от новородени, сочат данните на Изпълнителната агенция по трансплантации. Това се е случило в последните години. Все повече родители пристъпват към съхраняване на клетки от пъпната връв на бебетата си.
За 2008 година са съхранени 1 239 проби, през 2009 г. те са 1 139 през 2010 г. – 1 378, а за 2011-а – 1 370 проби със стволови клетки от пъпна връв и 119 от периферна кръв. Общо за десет години обаче цифрата е вече 25 217, съобщи шефката на агенцията д-р Мариана Симеонова.
Ако искате да застраховате детето си от смъртоносни болести, трябва да се бръкнете със 7000 лева, пише „Монитор“. Толкова струва процедурата за добиване на стволови клетки от пъпната връв на бебето при раждане. 25 217 родители замразиха материал от новородените си бебета в последните десет години. Толкова са взетите проби от 2007 до 2017 година, съобщи директорката на Изпълнителната агенция по трансплантациите д-р Мариана Симеонова.
Половината от пробите – 14 081, са взети от частни банки с представителства у нас, поясни д-р Симеонова. 11 049 са от тъкан на пъпна връв, а в последните пет години са взети и 87 проби на мезинхимни стволови клетки от млечни зъбчета.
Колко от тези проби са били размразени, за да се спаси живот, Агенцията не може да каже, понеже не разполага с тези данни. Причината е, че според Закона за трансплантациите чуждестранните банки нямат задължение да дават подобни сведения. Техният ангажимент е само да подадат информация за взети проби за съхранение от български граждани. Но и това важи само за тези, които имат свои представителства у нас.
На практика те оформят документите и взимат пробите, но ги изпращат за съхранение зад граница, където са централите им.
От 2007 г. към момента са взети 452 проби стволови клетки от пъпна връв на новородени, които са предоставени на Националната публична донорска банка, базирана в Александровска болница. За разлика от частните чуждестранни структури взимането на материала и съхраняването му в нея е безплатно. Той обаче не се пази само за хора от семейството на дарителя и се предоставя на нуждаещ се реципиент независимо кой е той.
Между 6000 и 7000 лв. е цената за взимане на проби в частните банки за стволови клетки. Някои клиники са свалили цената на 3000 лева, но отделно от това за всяка година съхранение клиентите плащат 130 – 150 евро, като могат да броят сумата и в левове.
Клетките, независимо дали са взети от пъпната връв, от кръв или от зъбче, се замразяват в течен азот при минус 150 градуса по Целзий в Дюарови съдове. Съхранението е за 15-20 години по желание на клиента. Този срок е приет за страните от Европейския съюз.
С трансплантацията на стволови клетки се лекуват 80 тежки болести като левкемия, ревматоидни заболявания, диабет от втори тип и анемии. Те са и отличен материал за заличаване на тежки, обезобразяващи белези.
Въпросните количества са взети предимно от частни банки за стволови клетки с представителства в България. У нас се добива само материалът, съхраняването му е в чужбина. Спасителният лек се предоставя при необходимост със заявка от клиента и придружаваща епикриза от лекуващия лекар.